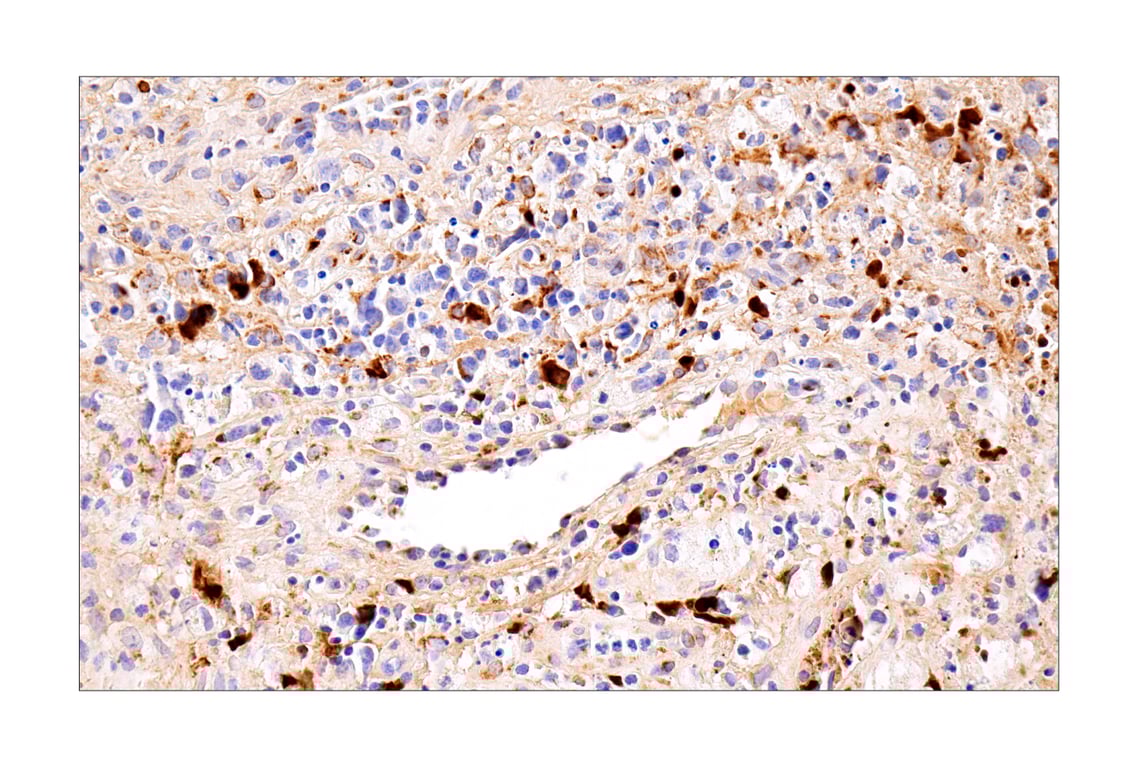

マイストア
変更
お店で受け取る
(送料無料)
配送する
納期目安:
2025.09.21 21:45頃のお届け予定です。
決済方法が、クレジット、代金引換の場合に限ります。その他の決済方法の場合はこちらをご確認ください。
※土・日・祝日の注文の場合や在庫状況によって、商品のお届けにお時間をいただく場合がございます。
namiiiii様 PE/Cyanine7 anti-mouse CD63 Antibody anti-CD63 - NVG-2の詳細情報
PE/Cyanine7 anti-mouse CD63 Antibody anti-CD63 - NVG-2。Lamin A/C (4C11) Mouse mAb (BSA and Azide Free) | Cell。CXCL9/MIG (E6Z5W) Rabbit mAb | Cell Signaling Technology。長い間オーダーを停止してしまい申し訳ありません。CXCL9/MIG (E6Z5W) Rabbit mAb | Cell Signaling Technology。これからまたたくさんのお財布ちゃんたちを作っていきたいと思います!^ ^どうぞ宜しくお願い致します!オーダー受付ます。ブラシの平野 手植え水雷型 馬尾毛100%。⚪︎長財布*オーダー料*コンチョ*両端Dカン*送料全て込みでお値段→(¥7320-)となります。大巡礼★富を築き理想の人生へブレスチャージ可オルゴナイト。2025年6月のオーダーより仕入れ生地やデニム生地の価格高騰により大変心苦しいですが¥6520-→¥7320-に変更しています。負の連鎖を断ち切り新たな人生を切り開く守り勾玉オルゴナイト。プラス料金になってしまいますが画像のようにダブルファスナーに変更やタッセルなどもお付けすることが可能です‼︎♡裏地は基本ブラックになりますがカラー生地への変更も可能です^ ^オーダーものですので一点物になります(*^^*)お気に入りのお財布ができるよう一生懸命お作りさせていただきます(*^^*)ハンドメイド品になります。ピーチ。既製品のような完璧な品物ではございませんハンドメイドならではの味やあたたかみをたのしんでいただけたらなとおもいます(*^^*)♡オーダー完成には打ち合わせ完了後2週間ほどお時間いただいております(*^^*)気になることや質問などお気軽にコメントください(*^^*)♡素敵なご縁がありますように。大巡礼.美貌を手に入れ理想の人生へ美人観音持ち運びオルゴナイト。デニムリメイク デニム財布財布お財布バックお財布ポシェットリーリーバイス
ベストセラーランキングです
近くの売り場の商品
カスタマーレビュー
オススメ度 4.8点
現在、4108件のレビューが投稿されています。

![自転車「アフリカバイクプログラム」[Kona /Africa bike ]](https://static.mercdn.net/item/detail/orig/photos/m93522159429_1.jpg)







